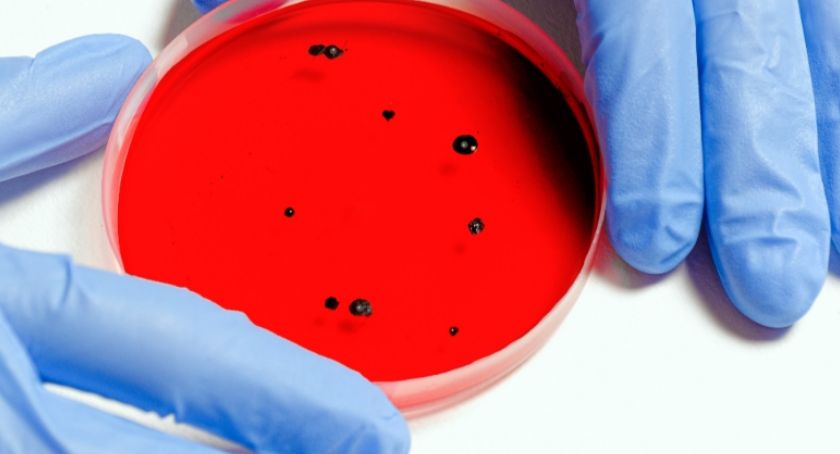

Nieoficjalnie: Ujemny wynik testu na obecność koronawirusa u pacjentki z SOR
Jak już informowaliśmy, w środę popołudniu (11.03) na oddział ratunkowy szpitala w Szczecinku trafiła mieszkanka Bornego Sulinowa z objawami infekcji spowodowanej przez koronawirusa. Jak się dowiadujemy, wynik testu na obecność wirusa jest ujemny.
Pacjentka w środę, 11.03 została przywieziona karetką do szpitala w Szczecinku z objawami groźnego koronawirusa, wcześniej przebywała w Niemczech. Następnie przetransportowano ją na oddział zakaźny w Szczecinie, gdzie wykonano niezbędne badania i test na obecność wirusa w organizmie kobiety.
Jak poinformowali w trakcie konferencji prasowej w starostwie Wiesław Kulik, szef szczecineckiego sanepidu oraz Anna Złotowska, prezes szczecineckiego szpitala, na wyniki oficjalne trzeba jeszcze trochę poczekać. Dyrektor medyczny szpitala otrzymał jednak telefoniczną informację, że wynik pacjentki jest ujemny. Kobieta najprawdopodobniej zostanie przetransportowana do szpitala w Szczecinku.
Patryk Witczuk
Obserwuj nas na  Google News
Google News
Chcesz być na bieżąco z wieściami z naszego portalu? Obserwuj nas na Google News!
Komentarze opinie
Podziel się swoją opinią
Twoje zdanie jest ważne jednak nie może ranić innych osób lub grup.
Komentarze
-
Reklama
-
 gość 2020-03-13 11:45:02
gość 2020-03-13 11:45:02niech wraca do niemcowni się leczyć, nie do nas!
odpowiedz- Zgłoś wpis
-
 Gość - niezalogowany 2020-03-13 12:12:48
Gość - niezalogowany 2020-03-13 12:12:48Pisałem że chora na serce siejącym panikę nie tej kobiecie winna być wymierzona kara
odpowiedz- Zgłoś wpis
-
 Gość - niezalogowany 2020-03-13 15:51:59
Gość - niezalogowany 2020-03-13 15:51:59Kobieta była u córki w Niemczech to niby czemu ma tam wracać?
odpowiedz- Zgłoś wpis
-
Reklama
-
 Gość - niezalogowany 2020-03-13 17:12:44
Gość - niezalogowany 2020-03-13 17:12:44Wspaniale, że wykluczono najgorsze. Życzę tej Pani szybkiego powrotu do zdrowia.
odpowiedz- Zgłoś wpis
Wideo Temat Szczecinecki Temat.net
- Dzisiejsze 0
- Motoryzacja 42
- Nieruchomości 32
- Praca 13
- Usługi i firmy 10
- Dom i ogród 9
- Elektronika / AGD 9
- Moda 7

















niech wraca do niemcowni się leczyć, nie do nas!
Pisałem że chora na serce siejącym panikę nie tej kobiecie winna być wymierzona kara
Kobieta była u córki w Niemczech to niby czemu ma tam wracać?